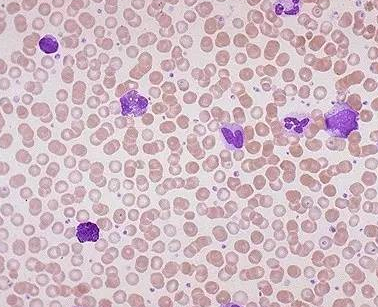

【资讯导读】威托克是一种口服B细胞淋巴瘤因子-2(BCL-2)抑制剂,威托克的活性药物成分。威托克旨在选择性抑制BCL-2的功能,恢复细胞的通讯系统,使癌细胞自毁,达到治疗肿瘤的目的。Gazyva活性药
威托克是一种口服B细胞淋巴瘤因子-2(BCL-2)抑制剂,威托克的活性药物成分。威托克旨在选择性抑制BCL-2的功能,恢复细胞的通讯系统,使癌细胞自毁,达到治疗肿瘤的目的。Gazyva活性药物成分为Obinutuzumab,这是第一种糖基化的二型抗CD20单克隆抗体。它靶向B细胞表面的CD20分子,并能直接诱导B细胞死亡。
CLL14是一项前瞻性、多中心、开放标签、随机研究,与德国CLL研究小组(DCLLSG)合作进行,旨在评估VG方案与标准护理方案相比的疗效和安全性,后者是针对以前未接受治疗且有并发症的CLL患者的VC一线治疗。共有445名患者被纳入研究。根据国际慢性淋巴细胞性白血病研讨会(iwCLL)标准,这些患者之前均未接受治疗。在这项研究中,患者接受了12个月的固定时间治疗。主要终点由研究者根据国际慢性淋巴细胞白血病标准评估,次要终点由独立审查委员会(IRC)、最小残留疾病(MRD)状态、总缓解率(ORR)、完全缓解率(CR)、总生存时间、缓解持续时间、无事件生存时间、下一次CLL治疗时间和安全性评估。中位随访时间为28个月,结果显示:(1)与静脉注射组相比,静脉注射组的肺功能评分显著延长,疾病进展或死亡的风险显著降低65%。在2年时(即停止治疗后1年),VG方案组中较高比例的患者保持无进展(88.2%对64.1%),研究者评估的PFS中位数尚未达到。(2)与VC方案组相比,VG方案组在所有次要终点显示出一致的临床益处,包括至少部分血细胞计数恢复的ORR(84.7%对71.3%)和CR(49.5%对23.1%)。
治疗3个月后,与威托克组相比,威托克骨髓MRD阴性(56.9%对17.1%)和外周血MRD阴性(75.5%对35.2%)的患者比例较高。MRD阴性定义为10,000个白细胞中少于一个CLL细胞。(4)4)VG方案的安全性与单一药物的已知安全性特征一致,并且在联合治疗中没有发现新的安全性信号。VG方案组和VC方案组常见的3/4级不良事件为低白细胞计数(52.8%对48.1%)和感染(17.5%对15.0%),两组之间具有可比性。威托克联合加Gazyva线治疗慢性淋巴细胞白血病的良好实验数据的发布,为患有此类疾病的患者带来了新的治疗选择。
威托克药品详细信息请进入:https://www.inmedf.com/zhongliu/bxb/20201419.html